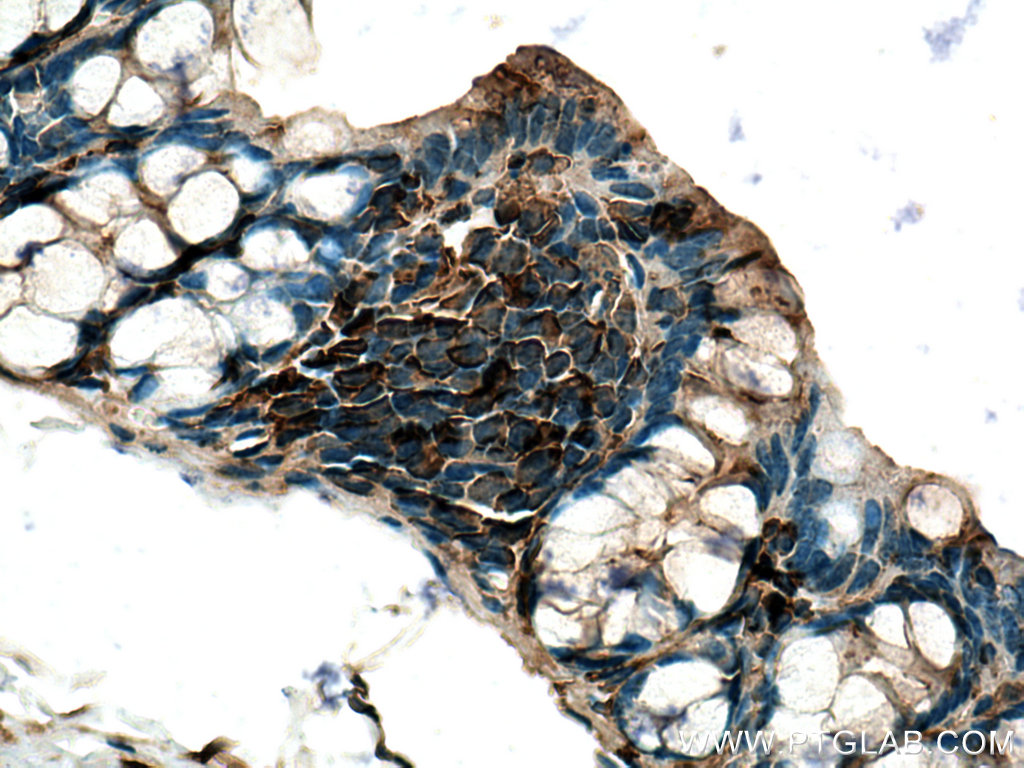

验证数据展示
经过测试的应用
| Positive IP detected in | mouse skeletal muscle tissue |
| Positive IHC detected in | mouse skeletal muscle tissue, mouse colon tissue Note: suggested antigen retrieval with TE buffer pH 9.0; (*) Alternatively, antigen retrieval may be performed with citrate buffer pH 6.0 |
| Positive IF-P detected in | mouse heart tissue |
推荐稀释比
| 应用 | 推荐稀释比 |
|---|---|
| Immunoprecipitation (IP) | IP : 0.5-4.0 ug for 1.0-3.0 mg of total protein lysate |
| Immunohistochemistry (IHC) | IHC : 1:50-1:500 |
| Immunofluorescence (IF)-P | IF-P : 1:400-1:1600 |
| It is recommended that this reagent should be titrated in each testing system to obtain optimal results. | |
| Sample-dependent, Check data in validation data gallery. | |
产品信息
19850-1-AP targets Thymosin beta 4 in WB, IHC, IF-P, IP, ELISA applications and shows reactivity with human, mouse, rat samples.
| 经测试应用 | IHC, IF-P, IP, ELISA Application Description |
| 文献引用应用 | WB, IHC, IF |
| 经测试反应性 | human, mouse, rat |
| 文献引用反应性 | human, mouse, chicken |
| 免疫原 |
CatNo: Ag13914 Product name: Recombinant human TMSB4X protein Source: e coli.-derived, PGEX-4T Tag: GST Domain: 1-63 aa of BC001631 Sequence: AQTRLRSYSCASLRFSSATMSDKPDMAEIEKFDKSKLKKTETQEKNPLPSKETIEQEKQAGES 种属同源性预测 |
| 宿主/亚型 | Rabbit / IgG |
| 抗体类别 | Polyclonal |
| 产品类型 | Antibody |
| 全称 | thymosin beta 4, X-linked |
| 别名 | TMSB4X, TB4X, T beta-4, T beta 4, PTMB4 |
| 计算分子量 | 63 aa, 7 kDa |
| 观测分子量 | 5 kDa |
| GenBank蛋白编号 | BC001631 |
| 基因名称 | Thymosin beta 4 |
| Gene ID (NCBI) | 7114 |
| RRID | AB_10642437 |
| 偶联类型 | Unconjugated |
| 形式 | Liquid |
| 纯化方式 | Antigen affinity purification |
| UNIPROT ID | P62328 |
| 储存缓冲液 | PBS with 0.02% sodium azide and 50% glycerol, pH 7.3. |
| 储存条件 | Store at -20°C. Stable for one year after shipment. Aliquoting is unnecessary for -20oC storage. |
背景介绍
Thymosin beta 4 (Tβ4), encoded by TMSB4X gene, is an actin sequestering protein which plays an important role in the organization of the cytoskeleton. Numerous studies have demonstrated the effects of Tβ4 on cell migration, proliferation, apoptosis and inflammation after exogenous treatment (PMID: 22652458). Recently, novel findings provided compelling evidence that Tβ4 played a key role in facilitating tumor metastasis and angiogenesis. It has been found that Tβ4 expressed increasingly in a number of metastatic tumors, thus providing a potential target of opportunity for cancer management, especially for cancer metastasis therapy (PMID: 22856429).
实验方案
| Product Specific Protocols | |
|---|---|
| IF protocol for Thymosin beta 4 antibody 19850-1-AP | Download protocol |
| IHC protocol for Thymosin beta 4 antibody 19850-1-AP | Download protocol |
| IP protocol for Thymosin beta 4 antibody 19850-1-AP | Download protocol |
| Standard Protocols | |
|---|---|
| Click here to view our Standard Protocols |
发表文章
| Species | Application | Title |
|---|---|---|
Adv Sci (Weinh) Tβ4-Engineered ADSC Extracellular Vesicles Rescue Cell Senescence Through Separable Microneedle Patches for Diabetic Wound Healing | ||
Nat Commun Single-cell transcriptomic analysis of the tumor ecosystems underlying initiation and progression of papillary thyroid carcinoma | ||
Front Med Distinct immune escape and microenvironment between RG-like and pri-OPC-like glioma revealed by single-cell RNA-seq analysis | ||
J Mol Cell Biol Nanog suppresses cell migration by downregulating thymosin β4 and Rnd3.
| ||
Haematologica Thymosin β4 is essential for thrombus formation by controlling the G-actin/F-actin equilibrium in platelets.
|